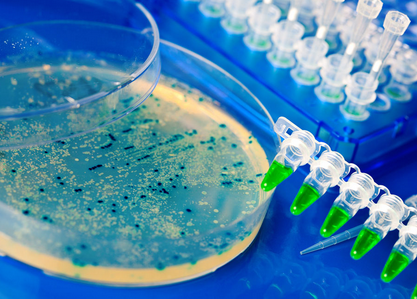

如何提升碳纤维制品的耐腐蚀性?
除了质量轻强度高等特性外,碳纤维复合材料在耐腐蚀性能方面比传统金属的表现也要更加出色。根据央视网报道,胜利油田滨南采油厂的一口油井,之前由于含硫量高,普通钢杆撑不到两个月就被腐蚀得无法工作,因而被迫关停,使用碳纤维杆后,油井起死回生,至今已连续稳定运行600余天。使用碳纤维复合材料制成的抽油杆不仅能省电,其极佳的抗腐蚀性能能经得住油井中硫的腐蚀,使用时间比金属杆更长。那么,碳纤维复合材料为什么会具有这么强的耐腐蚀性呢?其耐腐蚀性能是由哪些因素决定的呢?

首先,碳纤维材料本身就具有很强的耐腐蚀性。碳纤维是经过2000—3000℃高温石墨化处理形成的类似石墨晶体的微晶结构,这种结构本身就具有很高的耐介质腐蚀性,在高达50%的盐酸、硫酸或者磷酸中亦能在弹性模量、强度和直径等方面基本保持无变化。因此,作为增强材料来说,碳纤维在耐腐蚀性能方面有足够的保证。
但是,实际应用中的碳纤维复合材料制品在耐腐蚀性能方面还存在着很大的差异,因为和碳纤维结合使用的树脂基体以及碳纤维与树脂之间的界面等种种因素都会对碳纤维复合材料制品的耐腐蚀性造成影响。

与碳纤维结合使用的不同基体树脂在耐腐蚀性上有所区别,在不同环境中以及在不同环境下的工作时间也会造成碳纤维复合材料制品不同的耐腐蚀性表现。如最常见的碳纤维增强环氧树脂基,其在不同环境下长期存放后,仍能较好地保持弯曲强度,因为环氧树脂的耐候性较好。但是这种复合材料在亚湿热气候区及沿海地区的老化速度和程度比在温带、内陆和寒湿带要来的更加明显。因为,紫外线、氧气和潮湿的综合性作用在环境对环氧树脂复合材料的老化作用中,比单方面的作用力更强。老化的过程往往是从环氧树脂复合材料的表面开始,然后逐步向其内部进行扩展。
那么,如何有效提升碳纤维制品的耐腐蚀性呢?如果在环氧树脂碳纤维复合材料的表面涂漆膜或是粘贴能吸收紫外线的透明薄膜,或者在基体中添加增加耐候性的助剂等等,都能有效提高碳纤维复合材料的耐腐蚀性能。

在设计和使用碳纤维复合材料时,大分子结构中含有体型结构、苯环、杂环,分子间能形成氢键结晶性高聚物的树脂基体是增强碳纤维复合材料制品耐腐蚀性较好的选择,另外,制品具体的加工工艺对其耐腐蚀性也有一定的影响,我公司在多年的碳纤维复合材料制品研发过程中发现,碳纤维复合材料制品在制造过程中,在满足性能要求的前提下尽可能地提高制品的固化程度将有效提高制品的耐腐蚀性。

应用实际也表明,在碳纤维环氧树脂复合材料制品的成型过程中,界面状态及界面区域的形成是提高其产品耐介质腐蚀性能的关键。加强对碳纤维复合材料制品的表面处理对其防腐蚀性能的影响是直接的,有效的表面处理既可以保护纤维表面,又能增强纤维与树脂界面的粘接力,从而防止水分或其他有害介质的侵入。通过改善界面粘结性能,提高复合材料的界面粘结强度,可降低孔隙率和结构缺陷,使得腐蚀介质不易渗透、扩散。除此之外,无锡威盛新材料科技有限公司的研发团队对经过不同表面处理的碳纤维复合材料制品进行对比测试,结论显示,设计合理的耐腐蚀层,如足够的富树脂防渗层以及使用玻璃鳞片涂料等,都是可供选择的处理方式。
当然,碳纤维复合材料制品具体的应用环境不同,制品所需要应对的腐蚀性因素也各不相同,例如,应用在医疗器械上的碳纤维复合材料需要应对的是医用环境下的腐蚀因素,应用在汽车和轨道车辆上的碳纤维复合材料需要应对的是复杂交通环境中可能遇到的种种腐蚀因素,甚至是可以具体到上述不同油井中特定的化学成分的腐蚀。我们认为,在碳纤维复合材料制品的开发过程中针对具体的应用环境及腐蚀因素对制品的设计与开发作出相对应的处理,将有效提高碳纤维制品的应用价值。
随着碳纤维复合材料制品应用技术的发展,在许多环境恶劣的工作场景下,碳纤维复合材料良好的耐腐蚀性为其赢得了越来越多的应用机会。即便是在正常的工作环境中,这种性能优势也能有效延长制品的使用寿命,为其进一步取代传统金属制品实现“轻量化”带来更多的可能,因此,有效提升碳纤维制品的耐腐蚀性意义重大。
(版权所有,转载时请务必保持内容的完整性并标明文章出处。)






